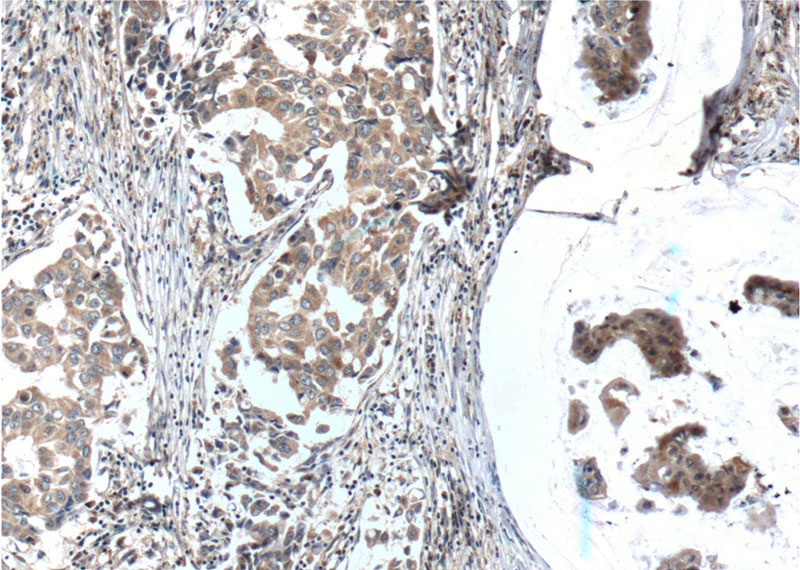

-
Product Name
SURVIVIN antibody
- Documents
-
Description
SURVIVIN Rabbit Polyclonal antibody. Positive IF detected in HeLa cells. Positive IHC detected in human breast cancer tissue, human colon cancer tissue, human gliomas tissue, human lung cancer tissue, human pancreas cancer tissue, rat brain tissue. Positive WB detected in PC-3 cells, A431 cells, A549 cells, Jurkat cells, MCF7 cells. Positive IP detected in Jurkat cells. Observed molecular weight by Western-blot: 16-18 kDa
-
Tested applications
ELISA, WB, IF, IP, IHC
-
Species reactivity
Human, Rat; other species not tested.
-
Alternative names
API4 antibody; Apoptosis inhibitor 4 antibody; Apoptosis inhibitor survivin antibody; BIRC5 antibody; EPR 1 antibody; IAP4 antibody; SURVIVIN antibody
-
Isotype
Rabbit IgG
-
Preparation
This antibody was obtained by immunization of SURVIVIN recombinant protein (Accession Number: NM_001168). Purification method: Antigen affinity purified.
-
Clonality
Polyclonal
-
Formulation
PBS with 0.02% sodium azide and 50% glycerol pH 7.3.
-
Storage instructions
Store at -20℃. DO NOT ALIQUOT
-
Applications
Recommended Dilution:
WB: 1:200-1:2000
IP: 1:200-1:1000
IHC: 1:50-1:500
IF: 1:10-1:100
-
Validations

PC-3 cells were subjected to SDS PAGE followed by western blot with Catalog No:115749(SURVIVIN antibody) at dilution of 1:1000
Immunohistochemistry of paraffin-embedded human breast cancer tissue slide using Catalog No:115749(SURVIVIN Antibody) at dilution of 1:200 (under 10x lens). heat mediated antigen retrieved with Tris-EDTA buffer(pH9).

Immunohistochemistry of paraffin-embedded human breast cancer tissue slide using Catalog No:115749(SURVIVIN Antibody) at dilution of 1:200 (under 40x lens). heat mediated antigen retrieved with Tris-EDTA buffer(pH9).

IP Result of anti-SURVIVIN (IP:Catalog No:115749, 4ug; Detection:Catalog No:115749 1:300) with Jurkat cells lysate 2120ug.

Immunofluorescent analysis of HeLa cells using Catalog No:115749(SURVIVIN Antibody) at dilution of 1:25 and Alexa Fluor 488-congugated AffiniPure Goat Anti-Rabbit IgG(H+L)
-
Background
Survivin, also called BIRC5, is a unique member of the inhibitor of apoptosis (IAP) protein family. Survivin is a 16 kDa anti-apoptotic protein highly expressed during fetal development and cancer cell malignancy, but is completely absent in terminally differentiated cells. The differential expression of survivin in cancer versus normal tissues makes it a useful tool in cancer diagnosis and a promising therapeutic target. Survivin expression is also highly regulated by the cell cycle and is only expressed in the G2-M phase. It is known that survivin localizes to the mitotic spindle by interaction with tubulin during mitosis and may play a contributing role in regulating mitosis. Disruption of survivin-microtubule interactions results in loss of survivin's anti-apoptosis function and increased caspase-3 activity, a mechanism involved in cell death, during mitosis. It also is a direct target gene of the Wnt pathway and is upregulated by beta-catenin.
-
References
- Wu J, Chen W, Yin Y, Zheng Z, Zou G. Probing the cell death signaling pathway of HepG2 cell line induced by copper-1,10-phenanthroline complex. Biometals : an international journal on the role of metal ions in biology, biochemistry, and medicine. 27(3):445-58. 2014.
- Yu B, Tang C, Yin C. Enhanced antitumor efficacy of folate modified amphiphilic nanoparticles through co-delivery of chemotherapeutic drugs and genes. Biomaterials. 35(24):6369-78. 2014.
- Zhang MZ, Li C, Fang BY. High transfection efficiency of quantum dot-antisense oligonucleotide nanoparticles in cancer cells through dual-receptor synergistic targeting. Nanotechnology. 25(25):255102. 2014.
- Li X, Liu X, Xu Y. KLF5 promotes hypoxia-induced survival and inhibits apoptosis in non-small cell lung cancer cells via HIF-1α. International journal of oncology. 45(4):1507-14. 2014.
- Li X, Liu X, Xu Y, He Y, Liu J, Xie M. Expression profile of apoptotic and proliferative proteins in hypoxic HUVEC treated with statins. International journal of oncology. 46(2):677-84. 2015.
- Cotroneo E, Ashek A, Wang L. Iron homeostasis and pulmonary hypertension: iron deficiency leads to pulmonary vascular remodeling in the rat. Circulation research. 116(10):1680-90. 2015.
- Huang W, Liu J, Feng X. DLC-1 induces mitochondrial apoptosis and epithelial mesenchymal transition arrest in nasopharyngeal carcinoma by targeting EGFR/Akt/NF-κB pathway. Medical oncology (Northwood, London, England). 32(4):115. 2015.
- Zhao X, Fang Y, Yang Y. Elaiophylin, a novel autophagy inhibitor, exerts antitumor activity as a single agent in ovarian cancer cells. Autophagy. 11(10):1849-63. 2015.
Related Products / Services
Please note: All products are "FOR RESEARCH USE ONLY AND ARE NOT INTENDED FOR DIAGNOSTIC OR THERAPEUTIC USE"
